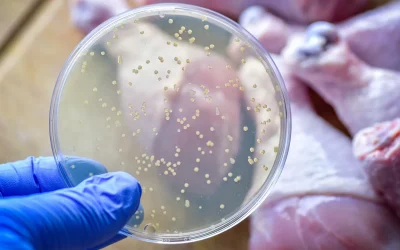
Arrivano i cerotti pieni di virus che riescono a stanare e uccidere i batteri nel cibo contaminato, ecco come funzionano

L’efficienza energetica di un data center si misura attraverso il parametro Pue (power usage effectiveness). La prima fase del progetto punta a raggiungere un valore non superiore a 1,15, un risultato notevole se si considera che la perfezione teorica è pari a 1,0. Per confronto, la normativa cinese stabilisce che entro il 2025 i nuovi data center dovranno restare sotto un Pue di 1,25.
L’impianto è progettato per essere sostenibile anche da altri punti di vista. Oltre il 95% dell’elettricità proviene da turbine eoliche offshore, e i progettisti stimano una riduzione complessiva dei consumi energetici del 22,8%. Come spiega Huang Dinan, presidente di Shenergy Group, un altro dei partner coinvolti, il Mar Cinese Orientale offre condizioni ideali per l’eolico, con più di 3mila ore di produzione annua. Inoltre, il sistema riduce di oltre il 90% l’uso del suolo – un vantaggio cruciale in aree densamente popolate come Shanghai – ed elimina del tutto il bisogno di acqua dolce.
Da Est a Ovest
Il data center sottomarino di Lin-gang non è un esperimento isolato. Rientra in una strategia nazionale più ampia, con cui Shanghai punta a diventare un polo mondiale per l’innovazione scientifica e tecnologica, facendo crescere l’industria del cloud computing fino a superare i 200 miliardi di yuan (circa 28,2 miliardi di dollari) entro il 2027.
L’iniziativa si inserisce nel contesto del megaprogetto nazionale “East Data, West Computing”, lanciato nel 2022 per trasferire parte dell’enorme carico di elaborazione dei dati dalle affollate città della costa orientale verso le regioni occidentali, dove l’energia costa meno e lo spazio non manca.
Il data center di Lin-gang adotta però una strategia diversa: invece di spostare le informazioni lontano dal punto d’origine, le elabora direttamente sul posto, sfruttando le risorse marine per garantire efficienza energetica e minore impatto ambientale.
I venti del cambiamento
La capacità di 24 megawatt del data center di Lin-gang rappresenta solo il punto di partenza. Durante la presentazione del progetto, i principali appaltatori – tra cui Shanghai Hicloud Technology, Shenergy Group, la filiale di China Telecom a Shanghai e Inesa – hanno firmato un nuovo accordo per costruire un secondo impianto sottomarino alimentato da energia eolica, con un obiettivo molto più ambizioso: raggiungere i 500 megawatt.
La vera sfida, però, sarà passare da un progetto sperimentale a un sistema operativo su vasta scala. Wang Shifeng, presidente di Third Harbor Engineering, una delle aziende coinvolte, ha ricordato che la costruzione di data center sottomarini è ancora agli inizi. Perché il modello si diffonda davvero, sarà necessario perfezionare la manutenzione, migliorarne l’affidabilità e dimostrare che può funzionare anche oltre la fase sperimentale.
Questo articolo è apparso originariamente su Wired en Español.